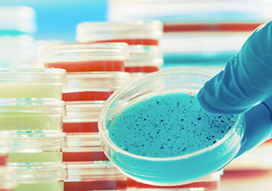
診断・試薬　受託サービス

バイオテクノロジーに関連する気になるカタログにチェックを入れると、まとめてダウンロードいただけます。
化 合物ライブラリーの提供とは?課題と対策・製品を解説

目的・課題で絞り込む
医薬・創薬
カテゴリで絞り込む
アカデミア/公的研究機関 |
医療・創薬 |
医療/診断/医療機器 |
化成品/化粧品 |
環境/エネルギー |
研究用機器・試薬・消耗品/設備 |
食品/農林水産/畜産 |
創薬支援/受託サービス |
知的財産/法務/金融 |
その他バイオテクノロジー |

医薬・創薬における化合物ライブラリーの提供とは?
各社の製品
絞り込み条件:
▼チェックした製品のカタログをダウンロード
一度にダウンロードできるカタログは20件までです。
医薬品業界における創薬研究では、新たな医薬品候補化合物の迅速な合成が求められています。反応条件の最適化や、多様な化合物の合成効率の向上が、研究の成功を左右する重要な要素です。マイクロ波合成装置は、反応時間を短縮し、より効率的な合成を可能にします。当社のマイクロ波合成装置は、創薬研究における課題解決に貢献します。
【活用シーン】
・医薬品候補化合物の合成
・反応条件の最適化
・化合物ライブラリの構築
【導入の効果】
・反応時間の短縮
・合成収率の向上
・意図しない副生成物を抑える
『Life Science Knowledge Bank』は、創薬候補となる化合物やターゲットを
効率良く探し出すソフトウェアです。
独自の活性データベースを中心にさまざまな手法を用いた多面的な
ターゲット探索を実現。さらに、個々のターゲットの評価が容易です。
また、既存のシステムとインテグレーションが可能です。
【特長】
■多様な場面で利用できる特長的な機能を搭載
■さまざまな手法を用いた多面的なターゲット探索を実現
■個々のターゲットの評価が容易
■多面的な探索を可能にする様々なコンテンツの要素へのテキストマイニング
■複雑な検索も単純化
※詳しくはPDF資料をご覧いただくか、お気軽にお問い合わせください。
当社は、総合試薬ディーラーとして学術研究機関、産業分野、医療分野など
様々なユーザーの皆様に貢献するために試薬・臨床検査薬・工業薬品・
理化学機器などの商品を提供してまいりました。
研究開発支援産業として科学技術の発達や技術革新に対応し、
お客様の求める情報の提供を行い、提案営業の推進を図ってまいりますので
ご要望の際はお気軽にお問い合わせください。
【事業分野】
■バイオ
■ケミカル
■臨床検査
■品質管理・分析
※詳しくはPDFをダウンロードしていただくか、お気軽にお問い合わせください。
スノーデン株式会社は、天然物を主体とした独創的な製品開発を行っております。
当社では、医薬品製造販売・健康食品・化粧品原料の販売及びOEM事業(商品開発・企画提案・製造受託)を行っています。
原料販売事業では、プラセンタエキスなど、天然素材に含まれる、
自然からの力を活かした特色ある原料をご提供致します。
また、OEM事業では、コンセプトや主成分・処方、形状の選択、
包装仕様や製造ロット、希望小売価格を打ち合わせや、販売に向けて
有効な情報提供とアドバイス等をご提案致します。
【事業内容】
■医薬品製造販売(ドラッグストアルート)
■原料販売(健康食品・化粧品・医薬部外品)
■OEM受託製造(健康食品・化粧品・医薬部外品)
※詳しくはカタログをご覧頂くか、お気軽にお問い合わせ下さい。
当社では、免疫・細胞培養・遺伝子操作関連分野における、豊富な技術と
経験の蓄積のもとに、免疫・細胞培養・遺伝子操作関連・研究の
アウトソーシングに貢献する業務を代行いたします。
受託の内容によっては、機密保持契約書を取り交わした上で実施可能。
また、抗体作製は、免疫から精製(または培養精製)は、本社内(国内)で
実施しておりますので、様々なご要望に対応いたします。
【サービス】
■ポリクローナル抗体作製
■ペプチド合成
■キャリアタンパク質結合
■モノクローナル抗体作製
■マウス腹水摂取
■抗体精製
■ELISA系の構築 など
※詳しくはPDFをダウンロードして頂くか、お気軽にお問合せください。
株式会社シン・コーポレーションでは、研究・開発で必要な試薬やキットなどの
供給元の調査やそれら研究用試薬の輸入販売を行っております。
供給元の調査・見積りは無料でお引き受けしますので、「この文献で使われた
この試薬、どこで買えるのか?」こういう時は、どうぞお気軽にお問合せください。
当社が試薬の検索から入手までをお手伝いいたします。
【特長】
■研究・開発で必要な試薬やキットなどの供給元の調査
■研究用試薬の輸入販売
■試薬の検索から入手までをお手伝い
※詳しくはPDF資料をご覧いただくか、お気軽にお問い合わせ下さい。
製造委託やCDMOの活用を検討されている企業様向けに、
契約・法務面での支援を提供しています。
製薬企業における製造・研究経験を活かし、以下のような支援に対応可能です:
• 製造委受託契約書(秘密保持契約含む)の作成・レビュー(和文/英文)
• 製造対象化合物の法規制チェック(薬機法・化審法・毒劇法など)
• 必要に応じて、委託先企業の選定支援や契約締結までの助言も可能
製造委受託に関する業務は、
お客様のご希望・必要性に応じて柔軟に対応いたします。
個人から中規模・大規模なワークグループまで、あらゆるユーザーに対応可能な統合薬品管理システムのご紹介です。
【特徴】
○毒物及び劇物取締法、安衛法、消防法等、あらゆる法規制に対応できる
○SDS、GHS等、様々な情報管理が可能
○電子天秤から直接、計測値を入力できる
○必要なデータを保持しているので高速動作ができる
○個人(1台)から研究所(255台)まで、どんな規模でも使える
○個人利用でも必要な環境を全てセットしたものを低価格で手に入れられる
○かんたんに操作できる
○Excel出力、帳票出力ができる
○研究者の要望から生まれた現場に即したシステム
○バイリンガル対応
詳細はカタログをダウンロードするか、お気軽にお問い合わせください。
当製品は、アズワン社製VIOLAMOタンパク質結晶化プレートの96ウェル
全てにゲルを予め分注したプレートです。
固相ゲル結晶化法を手軽に利用することができ、結晶化ロボットにも
適応することが可能です。
また、薬剤スクリーニングの効率化を図ることができるのも特長の1つです。
ゲル中結晶化作製用プレートとして、S、M、L、XLの4種類のサイズを
ご用意しております。
【特長】
■特許取得製品
■結晶の機械的強度が向上
■薬剤スクリーニングの効率化
■用途に合わせてお選びいただけるよう4種類のサイズをご用意
※詳しくはお問い合わせ、またはカタログをダウンロードしてください。
『INTENDD』は、汎用されているMD計算に基づいたドッキング法とは異なる
コンセプトに基づくインシリコ・テクノロジーです。
タンパク質間相互作用(PPI)を標的とした創薬研究で、高い性能を発揮。
当社独自のインシリコ創薬技術であり、一千万規模の化合物ライブラリから
200個程度のヒット候補化合物に絞り込むことが可能です。
【特長】
■低分子医薬品探索研究の成功確度を最大化
■ユニークな骨格を持つ多様な化合物の創出
■ナノモル・レベルでの正確な活性予測
■~20%のヒット率
■共同研究機会の拡大
※英語版カタログをダウンロードいただけます。
※詳しくはPDF資料をご覧いただくか、お気軽にお問い合わせ下さい。